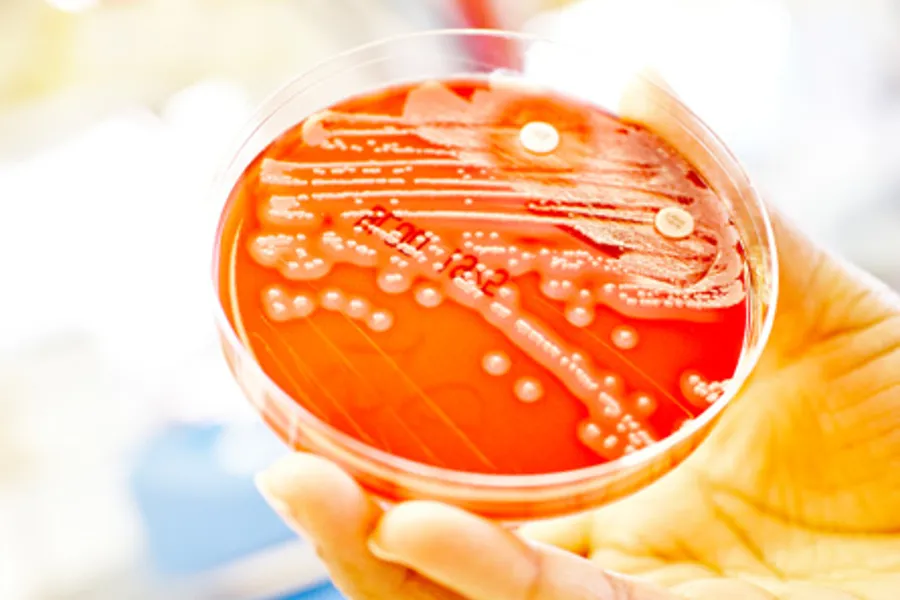

Praksisnytt
Endring av prøvetakingsutstyr mikrobiologi
Mikrobiogisk avdeling endrer nå noen typer prøvetakingsutstyr til mikrobiologiske prøver. Både ny og gammel type kan benyttes, men det er den nye typen som heretter blir levert når dere bestiller prøvetakingsutstyr.
UTGÅR: Transwab, lys blå kork (bruk opp det dere har) |
NY TYPE: ESwab, blå kork |
![]()
|
![]()
|
UTGÅR: Fecal transwab, mørk blå kork (bruk opp det dere har): |
NY TYPE: FecalSwab, grønn kork |
![]()
|
![]()
|
OBS: etikettene fra Dips interactor oppdateres med beskrivelse av de nye prøverørene. Siden ny og gammel type har forskjellig korkfarge vil beskrivelsen ikke stemme overens i overgangsperioden når dere bruker opp gammel type.
Ta kontakt med laboratorierådgiverne dersom dere har spørsmål 😊
Laboratorierådgivere: Telefon: Felles e-post:
Toril Holmøy Svendsen 90 96 36 69 brukerkontakt.lab@siv.no
Hasena Avdic 48 26 33 92
Julie Holmøy Helgesen 47 88 02 13